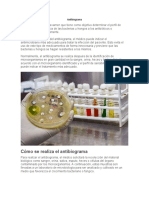

0% encontró este documento útil (0 votos)
22 vistas8 páginasPrevención y Tratamiento del COVID-19
El COVID-19, causado por el virus SARS-CoV-2, es una enfermedad respiratoria que puede ser leve a moderada, especialmente en personas mayores o con condiciones subyacentes. Se transmite principalmente a través de partículas líquidas de personas infectadas y presenta síntomas que varían en severidad. Las estrategias de prevención incluyen vacunación, buenas prácticas de higiene y tratamiento con medicamentos como Nirmatrelvir, Ritonavir y Remdesivir.
Cargado por
emilyacosta134Derechos de autor
© © All Rights Reserved
Nos tomamos en serio los derechos de los contenidos. Si sospechas que se trata de tu contenido, reclámalo aquí.
Formatos disponibles
Descarga como PPTX, PDF, TXT o lee en línea desde Scribd
0% encontró este documento útil (0 votos)
22 vistas8 páginasPrevención y Tratamiento del COVID-19
El COVID-19, causado por el virus SARS-CoV-2, es una enfermedad respiratoria que puede ser leve a moderada, especialmente en personas mayores o con condiciones subyacentes. Se transmite principalmente a través de partículas líquidas de personas infectadas y presenta síntomas que varían en severidad. Las estrategias de prevención incluyen vacunación, buenas prácticas de higiene y tratamiento con medicamentos como Nirmatrelvir, Ritonavir y Remdesivir.
Cargado por
emilyacosta134Derechos de autor
© © All Rights Reserved
Nos tomamos en serio los derechos de los contenidos. Si sospechas que se trata de tu contenido, reclámalo aquí.
Formatos disponibles
Descarga como PPTX, PDF, TXT o lee en línea desde Scribd